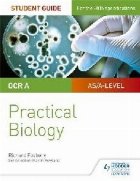
OCR level Biology Student Guide:

WJEC/Eduqas AS/A-level Year 1 Business Student Guide 1: Busi

AQA AS/A Level Year 1 Biology Workbook: Biological molecules

AQA AS/A Level Year 1 Biology Workbook: Organisms exchange s

AQA AS/A Level Year 1 Chemistry Workbook: Physical chemistry

AQA A Level Year 2 Biology Workbook: Energy transfers in and

AQA A Level Year 2 Biology Workbook: Genetics, populations,

AQA A Level Year 2 Chemistry Workbook: Physical chemistry 2

AQA A-Level Year 2 Chemistry Workbook: Inorganic and organic

OCR AS/A Level Year 1 Chemistry A Workbook: Foundations in c

OCR AS/A Level Year 1 Chemistry A Workbook: Energy; Core org

OCR A-Level Year 2 Chemistry A Workbook: Organic chemistry a

Edexcel A-level Year 2 Chemistry Student Guide: Topics 16-19

AQA A-level Year 2 Chemistry Student Guide: Physical chemist

CCEA AS Unit 2 Chemistry Student Guide: Further Physical and

AQA A-level Chemistry Student Guide: Practical Chemistry

AQA A-level Physics Student Guide: Practical Physics

Edexcel A-level Biology Student Guide: Practical Biology

AQA A-level Biology Student Guide: Practical Biology

OCR A-level Biology Student Guide: Practical Biology